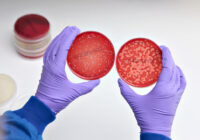

Азат тұрғындары қалай өмір сүреді?
2023 жылға арналған әлеуметтік-экономикалық көрсеткіштер бойынша Азат ауылында атқарылып жатқан жұмыстардың нәтижесі жөнінде аудан әкімі Самат Идрисовпен сұхбаттасқан едік. Өткен жылы электронды үкімет порталы арқылы жергілікті тұрғындардың 46 өтініші қабылданып, қаралды. Тұрғындарды негізінен жұмыспен қамту, абаттандыру және бұралқы иттерді аулау жөніндегі мәселелер толғандырады. Есепті кезеңде жергілікті қоғамдастықтың 7 жиыны және 9 жиналысы өткізіліп, онда инфрақұрылымды… Читать далее »